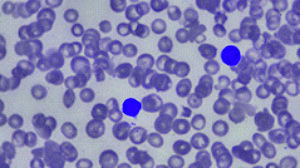
Figure from article: Chronic lymphocytic...

Current issue
Accepted manuscript
About the Journal
Scientific Council
Editorial Board
Regulatory and archival policy
Code of publishing ethics
Publisher
Information about the processing of personal data in relation to cookies and newsletter subscription
Archive
For Authors
For Reviewers
Contact
Reviewers
Annals reviewers in 2025
Annals reviewers in 2024
Annals reviewers in 2023
Annals reviewers in 2022
Annals reviewers in 2021
Annals reviewers in 2020
Annals reviewers in 2019
Annals reviewers in 2018
Annals reviewers in 2017
Annals reviewers in 2016
Annals reviewers in 2015
Annals reviewers in 2014
Annals reviewers in 2013
Annals reviewers in 2012
Links
Sklep Wydawnictwa SUM
Biblioteka Główna SUM
Śląski Uniwersytet Medyczny w Katowicach
Privacy policy
Accessibility statement
Reviewers
Annals reviewers in 2025
Annals reviewers in 2024
Annals reviewers in 2023
Annals reviewers in 2022
Annals reviewers in 2021
Annals reviewers in 2020
Annals reviewers in 2019
Annals reviewers in 2018
Annals reviewers in 2017
Annals reviewers in 2016
Annals reviewers in 2015
Annals reviewers in 2014
Annals reviewers in 2013
Annals reviewers in 2012
Keyword chronic lymphocytic leukemia
Chronic lymphocytic leukemia coexisting with polycythemia vera in a 67-year-old man: A case report
Ann. Acad. Med. Siles. 2026;80:104-108
Most read
Most cited
The Medical University of Silesia in Katowice, as the Operator of the annales.sum.edu.pl website, processes personal data collected when visiting the website. The function of obtaining information about Users and their behavior is carried out by voluntarily entered information in forms, saving cookies in end devices, as well as by collecting web server logs, which are in the possession of the website Operator. Data, including cookies, are used to provide services in accordance with the Privacy policy.
You can consent to the processing of data for these purposes, refuse consent or access more detailed information.
You can consent to the processing of data for these purposes, refuse consent or access more detailed information.

Article
Article 
